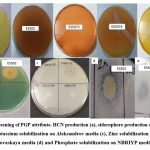
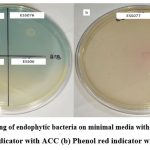

Introduction
Plants have diverse niche of pathogen, symbionts, epiphytes and endophytes.1 The term endophytes is applied to microorganism that spend whole life cycle within plant tissue and do not cause apparent infection and symptom of disease.2-3 The term “endophyte” was first used by De Bary in 1866. It derived from the Greek word “endon,” which means within, and “phyton,” which means plant. Endophytes can be found in all plant tissues, including the roots, stem, leaves, fruit, and seeds. The number of endophytes varies according to the tissue, the stage of development of the plant and the environment in which it lives. It is well recognized that endophytes are a promising source of a wide range of secondary metabolites with applications in industry, agriculture, and medicine.4 Current area of microbial research mainly focuses on plant microbes association and their role in production of valuable metabolites. Microorganism associated with medicinal plants act as reservoir of bioactive metabolites.5 Allium sativum (L.) have been cultivated since ancient times due to their medicinal properties such as antidiabetic, hypocholesterolemic, antilipidemic, fibrinolytic, anticancer and antimicrobial activity. Therefore, endophytes associated with these plant might be of interest to characterize for their medicinal importance 6-7 but unfortunately, less reports are available on the bacterial endophytes associated with these plant. Several studies have been conducted on bacterial endophytes associated with plants and their role in multiple plant growth promoting mechanisms such as the synthesis of plant hormones, ammonia, hydrogen cyanide, mineral solubilisation (P, K, Zn), siderophores, ACC deaminase activity, hydrolytic enzyme, secondary metabolites, and the induction of plant resistance mechanisms.8-9 Emerging research on bacterial endophytes, indicate that wide variety of bacterial species Bacillus, Azopirillum, Agrobacterium, Burkholderia, Rhizobium, Enterobacter, Pseudomonas and Azotobacter has magnificent plant growth promoting activity in different crop plant.10-11 Endophytic bacteria are emerging player as biocontrol agent to control the wilt disease.12 Fusarium oxysporum also cause wilt disease of various plant of economic importance including pigeon pea, chickpea and tomato. In India it causes serious problem related to production of legumes viz: pigeonpea, lentils and chickpea. Chickpea is second-most significant pulse crop in the world, chickpeas are grown on 10.2 million hectares of land and produce 7.9 million tons of pulses worldwide.13 Chickpea are rich in protein source for vegetarian’s people which cannot use meat as protein source. On the other hand lycopene, an antioxidant compound of high market value obtained from tomato plant which is also damaged by wilt fungi. Control of vascular wilt causing fungal pathogen is a challenging issue because there is no efficient treatment to cure the infected plants because they produce resting structure that can survive for long periods of time, due to which control of wilt disease is difficult.14 The disease symptoms can develop at any stage of plant growth and affect plants in patches or spread across a field. On full expression of disease the fungus blocks the xylem vessels and cause wilting and death of plant. Use of chemicals to control vascular wilt disease is expensive, ineffective and not ecofriendly.15 Therefore bacterial endophytes having antifungal activity can be used as a biocontrol agent to control the wilt disease. The present investigation revealed that Allium sativum plants are promising source of endophytic bacteria with biocontrol potential.
Materials and Methods
Collection of samples
Bacterial endophytes isolated from Allium sativum plants collected from different sites of district Jaunpur (25.5906° N, 83.0062° E) Uttar Pradesh, India. These plants were uprooted from field, placed in clean sterile plastic bag, brought to the laboratory and used for experimental purpose. For the isolation of endophytes bulbs (A. sativum) were washed with sterile distilled water.
Isolation of endophytic bacteria
In laboratory healthy Allium sativum plant were surface sterilized by using 70% C2H5OH (6 min), 3% NaOCl (1min) followed by C2H5OH (70%) treatment for 30 sec.16 After surface sterilization bulb were washed with sterile DW (distilled water) and cut into thin slices which was put on Nutrient Agar plate and incubated at 28±20C for 48-72 hrs for observing the possible microbial growth.17 The efficiency of sterilizer for Surface sterilization, was verified by inoculating final wash on control plate and incubated at 28±20C for 48-72 hrs and observed for possible microbial growth. Samples were used for isolation of endophytes when no growth appeared on control plate of final wash.
Production of Indole-acetic-acid
Bacterial endophytes were inoculated in nutrient broth amended with 50µg/ml tryptophan and without tryptophan for 4 days at 280C at 200rpm. After incubation the cells were harvested at 8000 rpm for 10min and IAA production was measured by using 1ml of supernatant, 2 drops of orthophosphoric acid and 4ml of Salkwoski reagent. Development of pink colour indicates formation of indolic compound was measured at 530nm.18
Ammonia, HCN and siderophore production
Ammonia production was done by inoculating culture into peptone broth and incubated for 4 days. After addition of Nessler’s reagent development of faint yellow to brownish colour indicates ammonia production.19 HCN production by bacterial endophytes were detected by using the method of Bakker and Schipper.20 Siderohore production were done by using method of Schwyn and Neilands (1987).21
Minerals solubilisation
Bacterial endophytes were inoculated on Pikovaskaya’s agar 2% (w/v) as well as on National Botanical Research Institute’s phosphate growth (NBRIP) medium and incubated at 28-300C for 3 to 7 days.22-23 Potassium solubilization by bacterial endophytes was screened on Aleksandrov media and modified Aleksandrov medium.24 Zinc solubilization by bacterial endophytes was screened on modified Pikovaskaya’s media amended with 0.1% zinc oxide (ZnO) and all the plates were incubated at 28-300C for 3 to 7 days.22 Mineral solubilization by bacterial endophytes were confirmed by formation of halo zone around colonies.
Screening of ACC (1-aminocyclopropane-1-corboxylate) deaminase activity
Bacterial endophytes were screened on modified ACC medium containing per liter: 4gm CaCO3, 2gm sodium citrate and 2gm potassium gluconate amended with 3 Mm ACC, instead of (NH4)2SO4 (nitrogen source). Improved screening method of ACC deaminase producing bacteria were done by using modified ACC media containing pH indicator dyes phenol red (0.005%) and bromothymol blue (0.008%). ACC deaminase activity releases ammonia and α-ketobutyrate that can be detected by change in colour of indicator around the colony of bacteria.25
Invitro screening of antifungal activity
The plant pathogen Fusarium oxysporum f. sp. ciceris (Foc) (NAIMCC-F-00856) were obtained from National Agriculturally Important Microbial Culture collection (NAIMCC), of ICAR-NBIAM, Mau, India. Antifungal activity of the bacterial endophyte were confirmed by dual-culture plate assay against Fusarium oxysporum f. sp. ciceris (Foc). Fungus disk (6mm) was put on centre of Petri plate containing Nutrient Agar:Potato Dextrose Agar (1:1) media. Bacterial endophytes were streaked on both sides of fungal disk and incubated at 28±20C for 5-6 days.26 Following formula were used to determined percent of mycelia growth inhibition
Mycelia growth inhibition (%) =(C-T/C) ×100
Where, C= radial fungus growth (mm) in control plate, and T= radial growth of fungus in treatment plate.
Pot experiment effect of Fusarium oxysporum on chickpea plants
Pot experiment was conducted in sterile soil (pH=7.2). The promising bacterial endophytes were grown on nutrient broth for 24-48 hrs at 28±20C and for seed treatment suspension of each endophytic bacteria were prepared in phosphate saline buffer (PBS) solution. Chickpea (Cicer arieinum L.) seeds were surface sterilized by using 1% NaOCl (sodium hypochlorite) for 5 minutes and then grow on 0.8% agar plates, similar size of germinated seed were dipped in PSB solution. Pathogen inoculum was added in the sterile soil and incubated for 25±2OC inside the polythene bag. The sterilized soil was filled in pot and inoculated with F.oxysporum f. sp. ciceris (Foc) at the rate of 5% (w:w). Surface sterilized seed were soaked in bacterial endophytes for 12 hrs.27 The treatments were (T1) Negative control (sterilized soil without F. oxysporum f. sp. ciceris), (T2) Positive control (F. oxysporum f. sp. ciceris only), (T3) ESS01+FO, (T4) ESS02+FO, (T5) ESS023+FO, (T6) ESS076+FO and (T7) ESS077+FO. Bacterial endophytes have plant growth promoting and inhibiting more than 70% mycelia growth were used for pot experiment. In pot experiment three replication were maintained for each treatment and seeds treated with each bacterial endophytes were sowed in each pot. Three seeds were sowed in each pot for the experiment, and after 25 days, 3 plants at random from each treatment were chosen. The growth characteristics of the plants, such as shoot and root length (cm) and shoot and root dry weight (gm/plant), were then measured. To determine the dry weight of shoot and root, the plants were dried in hot air oven at 600C for 48 hrs.
Molecular identification of bacterial endophytes
Genomic DNA of bacterial isolates were extracted from the bacterial /fungal DNA extraction kit following manufacturer’s protocol purchased by Nucleopore. 16S rRNA gene was amplified from selected isolates universal primers pA (8-27f) (5’- AGAGTTTGATCCTGGCTCAG-3’) and pH (1541-1522r) (5’ AAGGAGGTGATCCAGCCGCA-3’).28 Polymerase chain reaction was performed in 50 µl reaction volume containing 1× PCR buffer, 0.2Mm each of dNTP, 1.5pM each primer (pA and pH), 1.5 U of Taq DNA polymerase and DNA genomic DNA used as template. The PCR amplified DNA were eluted and purified by using Nucleo-pore sure extract PCR clean-up kit (Genetix Biotech Asia Pvt. Ltd) and finally sequenced by using BigDye terminator chemistry version 3.1 with an automated capillary sequencer (Applied Biosystems).The 16S rDNA sequence of the isolate was compared with sequence available by the BLASTn search in the database by using EzTaxon-Nezbiocloud (http:// www.eztaxon-e.ezbiocloud.net) to identify the nearest taxa.29 Phylogenetic tree were prepared by Neighbour-joining method using MEGA 11 software.30
The 13 endophytic bacterial isolates were characterized at molecular level and data were submitted to NCBI GenBank database, out of which data of eight isolates ESS03, ESS06, ESS024, ESSO25, ESS072, ESS073, ESS074, ESS075 has already been published (In press).31 Rest five with following accession number: ESS01 (OR574409), ESS02 (OR660402), ESS023 (OR603132), ESS076 (OR603152) and ESS077 (OR603148) communicated for publication.
Statistical analysis
The data were analysed by using ANOVA (one way analysis of variance) followed by Duncan’s multi-range test (DMRT). ANOVA was conducted using SPSS software, version 16.
Results
Isolation and characterization of bacterial endophytes
A total of thirteen endophytic bacteria were isolated from Jaunpur District of Uttar Pradesh having PGP and antifungal activity. All the bacterial endophytes were screened for their plant growth promotion as well as antifungal activity against plant pathogen. Molecular phylogeny of all 13 bacterial endophytes was performed and dendogram based on 16S rRNA sequence was generated (Fig 1). All the bacterial endophytes from Allium sativum were showed 99-100% similarity to Bacillus genus except ESS072 which showed 100% similarity with Klebsiella quasivariicola. The bacterial endophytes have antagonistic potential were classified as: Bacillus siamensis (ESS01, ESS06, ESS077), Bacillus velezensis (ESS074, ESS075, ESS076), Bacillus stercoris (ESS023, ESS025), Bacillus paralicheniformis (ESS024), Bacillus aerius (ESS02), Bacillus sp.(ESS03), Klebsiella quasivariicola (ESS072) and Bacillus safensis subsp. safensis (ESS073).
![]() |
Figure 1: Phylogenetic tree based on 16SrRNA nucleotide sequence by using Neighbor-joining method of bacterial endophytes from bulb of Allium sativum and those are closely related to strain (T) sequence. |
Plant growth promoting attribute of endophytic bacteria
The result of statistical analysis of PGP attribute of bacterial endophytes are listed in table 1. Tryptophan is main precursor for production of IAA. The IAA production of all the bacterial endophytes in presence of tryptophan were ranged between 24.19µg/ml to 10.79µg/ml and absence of tryptophan were ranged between 16.39µg/ml to 4.83µg/ml. ESS023 were exhibited maximum production of IAA in presence (24.19µg/ml) and absence of tryptophan (16.39µg/ml) whereas ESS072 exhibited minimum IAA production in presence of tryptophan as well as in absence of tryptophan (Fig 2).
![]() |
Figure 2: Quantitative estimation of IAA in presence (Trp+) and absence of tryptophan (Trp–). |
Among the 13 selected bacterial endophytes, all the strain have ability to produce ammonia whereas only four bacterial endophytes (ESS02, ESS073, ESS074, ESS075) gave positive result for HCN production while the other bacterial endophytes did not change the yellow color of alkaline picrate filter paper (Table 1 & Fig 3a). Only four (ESS02, ESS03, ESS023 and ESS76) bacterial endophytes have ability to produce siderophore which is reflected by yellow-orange halo zone (1.67-29.67mm) formation around the bacterial colony. ESS02 formed largest halo zone on chrome azurol sulfonate agar media and exhibited highest siderophore production (Table 1 and Fig 3b). Bacterial endophytes were assessed for minerals (P, K and Zn) solubilization and statically analyzed result were indicated in Table 1.
![]() |
Table 1: PGP attributes such as ammonia, HCN, siderophore production and mineral solubilization (P, K, Zn) by bacterial endophytes from bulb of Allium sativum. |
Only ESS02 was able to form transparent zone and have ability to solubilized P, K and Zn minerals on all the tested media. Further, it was observed that none of the bacterial endophytes were able to formed transparent zone on Pikivaskaya’s media whereas five endophytic bacteria (ESS01, ESS02, ESS024, ESS076 & ESS077) have ability to formed halo zone (1.33-8.33mm) on NBRIYP media (Fig 3e). Three bacterial endophytes (ESS02, ESS072 & ESS077) have ability solubilized potassium on Aleksandrov media and modified Aleksandrov media. ESS072 have strong potassium solubilization potential and formed largest zone (19.67mm) whereas ESS077 formed 2.00mm of solubization zone (Table 1 & Fig 3c). Indistinguishably, endophytic bacteria (ESS02, ESS076 & ESS077) were showed zinc solublization on modified Pikovaskaya’s media (Table1 & Fig 3d).
![]() |
Figure 3: Screening of PGP attribute. HCN production (a), siderophore production on CAS agar media (b), Potassium solubilization on Aleksandrov media (c), Zinc solubilization on modified Pikovaskaya media (d) and Phosphate solubilization on NBRIYP media(e). |
Screening of 1-aminocyclopropane-1-carboxylate deaminase (ACCD) producing endophytic bacteria
The bacterial endophytes isolated were capable to grow on both DF minimal medium supplied with nitrogen or without nitrogen source. Therefore, screening for ACC deaminase activity was done in modified medium containing ACC and pH indicator. ACC deaminase positive culture could produce enzyme ACC deaminase using ACC as a substrate to release NH4+. The production of ammonia is detected by formation of colored zone around colonies giving positive test. The potent producer of ACCD was identified on the basis of intense color zone around the colonies while little change was considered as moderate producer. In the case of no color change around the colony, less producer of ACC deaminase activity.
Table 2: Screening of endophytic bacteria on modified ACC media supplemented with ACC and pH indicator (bromothymol blue and phenol red).
| Bacterial endophytes | Qualitative estimation (ACC deaminase activity) |
| ESS01 | +++ |
| ESS02 | +++ |
| ESS03 | – |
| ESS06 | ++ |
| ESS023 | +++ |
| ESS024 | – |
| ESS025 | + |
| ESS072 | ++ |
| ESS073 | ++ |
| ESS074 | ++ |
| ESS075 | ++ |
| ESS076 | +++ |
| ESS077 | +++ |
| (-) No ACCD activity, (+) less ACCD activity, (++) moderate ACCD activity, (+++) high ACCD activity | |
A total of 13 bacterial endophytes selected were screened on minimal media with indicator dye (0.005% bromothymol blue & 0.008% phenol red). Among all screened bacterial endophytes 45% of isolates (ESS01, ESS02, ESS023, ESS076 & ESS077)) exhibited growth with intense color zone (maximum producer of ACCD), 45% of isolates (ESS06, ESS072, ESS074 & ESS075) colony with less intense color zone (medium producer of ACCD) and 9% of isolates produced colored colony without zone (least producer of ACCD) (Figure 4a,b & Table 2). 15% of bacterial endophytes are not able to grow on modified ACC media.
![]() |
Figure 4: Screening of endophytic bacteria on minimal media with (a) Bromothymol blue indicator with ACC (b) Phenol red indicator with ACC. |
In vitro screening of antifungal activity
The result of invitro antifungal activity of endophytic bacteria were isolated from bulb of Allium sativum indicated that among thirteen endophytic bacteria only ten bacteria inhibit the mycelia growth (>59%)of pathogenic wilt disease causing fungi Fusarium oxysporum (Foc). Analysis of variance showed significant antifungal effect of all endophytic bacteria as compared to control plate. The antifungal activity of all the tested endophytic bacteria against Fusarium oxysporum ranging from 59% to 74%. Analysis of variance showed antifungal effect of endophytic bacteria against Fusarium oxysporum as compared to control plate (p=0.05). ESS01 exhibited maximum antifungal activity against Fusarium oxysporum and inhibit >74% of mycelia growth (Table 3). The inhibition process may be related to secretion of fungicidal metabolites by endophytic bacteria.
Table 3: Antifungal activity of bacterial endophytes against Fusarium oxysporum f. sp. ciceris (Foc).
| S.no | Endophytes | F. oxysporum f. sp. ciceris (Foc) mycelia growth inhibition (%) |
| 1 | ESS01 (bulb of Allium sativum) | 74.81±0.64a |
| 2 | ESS02 (bulb of Allium sativum) | 71.48±0.64b |
| 3 | ESS03 (bulb of Allium sativum) | – |
| 4 | ESS06 (bulb of Allium sativum) | 70.37±1.69bc |
| 5 | ESS023 (bulb of Allium sativum) | 70.00±1.11bc |
| 6 | ESS024 (bulb of Allium sativum) | 60.37±1.28f |
| 7 | ESS025 (bulb of Allium sativum) | 70.00±1.11bc |
| 8 | ESS072 (bulb of Allium sativum) | – |
| 9 | ESS073 (bulb of Allium sativum) | – |
| 10 | ESS074 (bulb of Allium sativum) | 59.99±1.11f |
| 11 | ESS075 (bulb of Allium sativum) | 67.58±1.16de |
| 12 | ESS076 (bulb of Allium sativum) | 66.95±0.71e |
| 13 | ESS077 (bulb of Allium sativum) | 69.25±1.28cd |
Effects on bacterial endophytes on growth of chickpea seed
The effect of bacterial endophytes on growth of chickpea seed in presence of Fusarium oxysporum, five endophytes (ESS01, ESS02, ESS023, ESS076 and ESS077) were selected because of their availability of >66% inhibition of fungal mycelia growth (Table 3). The result of pot experiment (Table 4) revealed significant inhibition of F. oxysporum f. sp. ciceris (Foc) in seed treated with endophytic bacteria when compared with T1 (control without F. oxysporum i.e. negative control) and T2 (control with F. oxysporum f. sp. ciceris i.e. positive control) treatment. Treatment T4 (ESS02), T6 (ESS076) and T7 (ESS077) significantly increased the plant biomass. While ESS01 and ESS023 have the least impact on plant growth, T4 (ESS02) isolates showed higher mean values in terms of shoot length (18.82 cm), root length (9.55 cm), plant fresh weight (6.14 g), and dry weight (2.52 g). The treatment T3 and T5 of F. oxysporum f. sp. ciceris (Foc) has the lowest mean fresh and dry weight, as well as shoot and root length.
Table 4: The in vivo effect of endophytic bacteria on chick pea plant in pot experiment.
| Treatments | Shoot length (cm) | Root length (cm) | Fresh weight (g) | Dry weight (g) |
| T1: (sterilized soil without Foc) Negative control | 12.59 ± 0.08d | 5.26 ± 0.22 e | 2.60 ± 0.52d | 2.03 ± 0.05e |
| T2: Foc only (Positive control) | 3.09 ± 0.10e | 1.72 ± 0.23 f | 1.10 ± 0.01e | 0.74 ± 0.01f |
| T3:ESS01+Foc | 14.95 ± 0.04 c | 6.05 ± 0.03d | 5.49 ± 0.06b | 2.10 ± 0.01cd |
| T4:ESS02+Foc | 18.82 ± 0.17 a | 9.55 ± 0.48 a | 6.14 ± 0.13a | 2.52 ± 0.23a |
| T5:ESS023+Foc | 14.85 ± 0.08c | 6.46 ± 0.02c | 5.40 ± 0.43c | 2.23 ± 0.02bc |
| T6:ESS076+Foc | 15.99 ± 0.01b | 7.25 ± 0.06 b | 5.99 ± 0.005a | 2.38 ± 0.13ab |
| T7:ESS077+Foc | 16.08 ± 0.01b | 7.59 ± 0.06 b | 6.01 ± 0.01a | 2.40 ± 0.005ab |
Discussion
The bulb of Allium sativum was rich in diversity of endophytic bacteria. The endophytes were isolated from bulb of belonged to seven different Bacillus species and one belonged to Klebsiella species. Bacillus species is most important endophytic bacteria of different plants because they have ability to formed endospore and easily survive in adverse environment.32-34 In present investigation, thirteen endophtyic bacteria have antifungal as well as plant growth promoting activity. Molecular characterization of endophytic bacteria based on 16SrRNA analysis clearly indicate that Allium sativum have different strains of Bacillus siamensis, Bacillus velezensis, Bacillus stercoris, Bacillus aerius, Bacillus paralichniformis, Bacillus sp, Klebsiella quasivariicola and Bacillus safensis subsp. safensis. Similarly, these bacterial endophytes previously reported in different plant species such as Bacillus velezensis and Bacillus siamensis in tomato and chick pea plant.35, 36 Bacillus aerius were isolated from leaf of betel vine37, B. licheniformis in chenopodium quinoa38, K. variicola in sugarcane39 and Bacillus safensis in holy basil plant40 Among the several association occurring between two individual amensalism can be exploited as biocontrol agent to control plant pathogen. Chickpea seed are important source of protein, vitamin and minerals and widely used in India, which is the largest producer in the world. About 10 to 15 % yield of chickpea is reduced by F.oxysporum, which is wilt causing fungi.41 In order to control the plant pathogen biocontrol technique is ecofriendly approach. The plant is known from ancient times to control various infection. So, two of well-known medicinal plant, Allium sativum were used for isolation of endophytes and isolates were screened for their potential to inhibit the growth of wilt fungi. Microbial management of F.oxysporum by endophytic bacteria a potential tool to replace the various non-ecofriendly polluting chemicals. However, the exact mechanism of antagonistic activity of bacterial endophytes may include hydrogen cyanide production, siderophore production, hydrolytic enzyme and production of antifungal metabolite. Present investigation revealed that revealed that the endophytic bacteria Bacillus siamensis (ESS01, ESS06, ESS077), Bacillus velezensis (ESS074, ESS075, ESS076), Bacillus stercoris (ESS023, ESS025), Bacillus paralicheniformis (ESS024), Bacillus aerius (ESS02), Bacillus sp.(ESS03), Klebsiella quasivariicola (ESS072) and Bacillus safensis subsp. safensis (ESS073) are having antagonistic activity and inhibit ≥59% fungal mycelial growth of screened phytopathogenic fungi (Foc).
Plant growth generally decreased by due unviability of mineral nutrient like phosphorus, potassium and zinc as well as environmental stress.42 ESS02 and ESS077 have ability to solubilized nutrient (P, K, Zn) and also have ACC deaminase activity. ESS076, ESS077 have ability to solubilized the zinc whereas ESS072 have ability to solubilized potassium on Aleksandrov media. These result are confirmatory with previously obtained reports that different bacterial strain are significantly differ in their ability to solubilized mineral nutrient (P, K, Zn).43-44 Bacillus velezensis 8-4 isolated from healthy potato used to control the potato scab (S.galiaeus).45 Bacillus velezensis were isolated from bulb of Lilium leucanthum from china have antifungal as well as PGP traits (IAA, ammonia, siderophore, P solubilisation, ACC deaminase activity). The isolated endophytic bacteria inhibited 63.12±2.83% growth of F.oxysporum.46 Similarly in present investigation Bacillus velezensis strain (ESS074, ESS075, ESS076) exhibited PGP and antifungal activity. Bacillus velezensis ESS076 inhibited more than 65% mycelial growth of F.oxysporum and also increase root shoot length in pot experiment. In present investigation clearly evidence that ESS02, ESS076 and ESS077 have capability to supress the growth of plant pathogen and increase biomass of chick pea plant. The research finding are similar to previous report were co-inoculation of Bacillus siamensis and Priestia megaterium promote growth of rice.47 Bacillus siamensis also isolated from garlic from different site of China inhibited 19.64% growth of Sclerotium setonii causal agent of white rot disease.48 An important observation was that Bacillus aerius ESS02 have multiple PGP (ammonia, HCN, P, K, Zn, siderophore) as well as exhibit antifungal activity against F.oxysporum.
Achromobacter xyloxidans is endophytic bacteria isolated from Cucumis melo reduced significantly 80% of Fusarium mycelial growth and in greenhouse conditions it reduced 60% of disease severity on melon plants.49 Elanchezhiyan et al 2018 isolated twenty endophytic bacterial strains from various parts of tomato plant. The inhibition of fungal pathogen by some potential isolates varied from 48% to 39%.50 B. velezensis has been isolated from lotus found to be effective in controlling wilt disease caused by F. oxysporum.51 Plant growth promoting bacterial endophytes isolated from Arachis hypogaea exhibited antifungal activity.52 Endophytes isolated from medicinal plant Curcuma longa and Cassia tora also exhibit antifungal activity against Alternaria alternata, B.fulva and A. pullulans. 53-54 Bacterial endophytes obtained from Black pepper commonly known as the ‘King of Spices’ and root nodule of chickpea induce the suppression of fusarium wilt as well as root rot disease caused by F.solani.55-56 Recent studies indicate that F. oxysporum has expanded host range, implying the urgent need of effective management strategies.57 Several biocontrol agents has been identified and found to be effective against F.oxysporum and other plant pathogens.58-60 Thus, enhancing the probability of their application to be used as potential biocontrol agent.
Conclusion
In conclusion, the present investigation identified that the endophytic bacterial strains were isolated from Allium sativum have PGP trait with antifungal activity against wilt causing fungi. In future, these research finding will be useful for field application of Bacillus strains (Bacillus aerius ESS02, Bacillus velezensis ESS076, Bacillus siamensis ESS077) for ecofriendly crop production as well as to health management of hazardous chemical. Although, the present research finding is developing stage for formation of effective biocontrol agent. In future to support the present finding further field trial is required. These endophytic bacteria could be an alternative to the synthetic fungicides used for management of Fusarium wilt. These finding suggested that Allium sativum having endophytic bacteria that could be potential biocontrol and source of antimicrobial compound for further exploitation.
Acknowledgement
We gratefully acknowledge the Department of Science and Technology, Government of India, New Delhi for financial assistance under Women Scientist-A (WOS-A) scheme, File No. SR/WOS-A/LS-11/2018 to carry out this work.
Funding Sources
Funding provided by Department of Science and Technology, Government of India, New Delhi, vide File No. SR/WOS-A/LS-11/2018.
Conflict of Interest
The authors declare that there is no conflict of interest regarding the publication of this article.
Data Availability Statement
We can share our data if needed.
Ethical Clearance
The work reported in present study have no need of ethical clearance.
Informed Consent Statement
This research did not involve human participants, animal, subjects, or any material that requires ethical approval.
Author’s Contribution
RS and PS: conceptualization and design of the study, PS: wrote the manuscript and design figures and tables, SPT: Editing of manuscript AKS: Provided lab facility for some experimental work.
References
- Afzal I., Shinwari ZK., Sikandar S., Shahzad S. Plant beneficial endophytic bacteria: Mechanisms, diversity, host range and genetic determinants. Microbio Res; 2019; 221:36-49.
CrossRef - Wippel K. Plant and microbial features governing an endophytic lifestyle. Curr Opin Plant Biol; 2023; 76:102483.
CrossRef - Wilson D. Endophyte: the evolution of a term, and clarification of its use and definition. Oikos;1995; 73:274-276.
CrossRef - Ryan R.P., Germaine K., Franks A., Ryan D.J., Dowling D.N. Bacterial endophytes: recent developments and applications. FEMS Microbiol Lett;2008; 278:1–9.
CrossRef - Yu H., Zhang L., Li L., Zheng C., Guo L., Li W., Sun P., Qin L. Recent developments and future prospects of antimicrobial metabolites produced by endophytes. Microbio Res; 2010; 165:437-449.
CrossRef - Bayan L., Koulivand P.H and Gorji A.Garlic: a review of potential therapeutic effects. Avicen J phytomed; 2014; 4(1):1.
- Corzo-Martínez M., Corzo N., Villamiel M. Biological properties of onions and garlic. Trends in food sci & technol; 2007; 18(12):609-625.
CrossRef - Sukhwal, Jain D., Sharma V., Ojha SN., Jat G., Upadhyay S.K., Singh A., Mohanty S.R. Efficacy evaluation of newly isolated zinc solubilizing bacteria for their potential effect on maize (Zea mays L.) under zinc deficient soil conditions. Land degra develop; 2023; 34(16):4912-4923.
CrossRef - Chauhan PK., Upadhyay SK., Rajput VD., Dwivedi P., Minkina T., Wong M.H. Fostering plant growth performance under drought stress using rhizospheric microbes, their gene editing, and biochar. Environ Geochem Health; 2024; 46(2):41
CrossRef - Upadhyay S.K., Srivastava A.K., Rajput V.D., Chauhan P.K., Bhojiya A.A., Jain D., Chaubey G., Dwivedi P., Sharma B., Minkina T. Root Exudates: Mechanistic Insight of Plant Growth Promoting Rhizobacteria for Sustainable Crop Production. Front Microbiol; 2022; 13:916488.
CrossRef - Rani N., Chauhan A., Kaur S., Solanki M.K., Tripathi M., Jain D., Singh S., Upadhyay S.K., Kaur G. Molecular Mechanistic of Zn-Solubilizing Bacteria for Agronomic Eminence: Recent Updates and Futuristic Development. J Plant Growth Regul; 2023; 26:1-5.
CrossRef - Eljounaidi K., Lee S.K., Bae H. Bacterial endophytes as potential biocontrol agents of vascular wilt diseases–review and future prospects. Biol Contrl; 2016; 103:62-68.
CrossRef - FAO, 1994. Food and Agriculture organization of the United Nations Production Year Book, FAO, Rome Italy.
- Yadeta K.A., Thomma B.P. The xylem as battleground for plant hosts and vascular wilt pathogens. Front Plant Sci; 2013; 4:1–12.
CrossRef - Griffin M.R. Biocontrol and bioremediation: two areas of endophytic research which hold great promise. In: Verma, V.C., Gange, A.C. (Eds.), Adv in Endophy Res; Springer, India 2014; 257–282.
CrossRef - Srivastava P., Tiwari S.P., Sharma R. Optimization of surface sterilization process for isolation and cultivation of bacterial endophytes form Allium sativum. Mishra G, Dhawan, Gupta MK (Eds), In: Pro Int conf Ultra Mat Sci Adv Technol; 2019; Narosa Publishers, New Delhi; 189-194. ISBN: 978-81-8487-703-8.
- Boyle C., Gotz M., Dammann-Tugend U., Schulz B. Endophyte-host interaction III. Local vs. systemic colonization. Symbiosis 2001; 31(4): 259-281.
- Gordon S.A and Weber R.P. Colorimetric estimation of indoleacetic acid. Plant Physiol; 1951; 26(1):192–195.
CrossRef - Kavamura V.N., Santos S.N., da Silva J.L., Parma M.M., Ávila L.A., Visconti A., Zucchi T.D., Taketani R.G., Andreote F.D., de Melo I.S. Screening of brazilian cacti rhizobacteria for plant growth promotion under drought. Res; 2013; 168(4):183–191.
CrossRef - Bakker A.W., Schippers. Microbial cyanide production in the rhizosphere in relation to potato yield reduction and Pseudomonas spp-mediated plant growth-stimulation. Soil Bio Biochem; 1987; 19:451-7.
CrossRef - Schwyn B., Neilands J.B. Universal chemical assay for the detection and determination of siderophores. Anal Biochem; 1987; 160(1): 47–56.
CrossRef - Pikovaskaya R.I. Mobilization of phosphorus in soil in connection with the vital activity of some microbial species. Microbiologiya; 1948;17: 362-370.
- Nautiyal C.S. An efficient microbiological growth medium for screening phosphate-solubilizing microorganisms. FEMS Microbiol Lett; 1999; 170: 265-270
CrossRef - Rajawat M.V.S., Singh S., Tyagi S.P Saxena A.K. A modified plate assay for rapid screening of potassium-solubilizing bacteria. Pedosphere; 2016; 26(5):768-773.
CrossRef - Patil, C., Suryawanshi, R., Koli, S., Patil, S. Improved method for effective screening of ACC (1-aminocyclopropane-1-carboxylate) deaminase producing microorganisms. J Microbiol Meth; 2016; 131:102-104.
CrossRef - Jamali H., Sharma A., Roohi N., Srivastava A.K. Biocontrol potential of Bacillus subtilis RH5 against sheath blight of rice caused by Rhizoctonia solani. J Basic Microbial; 2020; 60:268-280.
CrossRef - Kushwaha P., Kashyap P.L., Srivastava A.K., Tiwari R.K. Plant growth promoting and antifungal activity in endophytic Bacillus strains from pearl millet (Pennisetum glaucum). B J Microbiol; 2020;51:229-241.
CrossRef - Edwards U., Rogall T., Blöcker H., Emde M., Böttger E.C. Isolation and direct complete nucleotide determination of entire genes. Characterization of a gene coding for 16S ribosomal RNA. Nucleic acids Res; 1989; 17(19):7843-7853.
CrossRef - Kim O.S., Cho Y.J., Lee K., Yoon S.H., Kim M., Na H., Park S.C., Jeon Y.S., Lee J.H., Yi H., Won S. Introducing EzTaxon-e: a prokaryotic 16S rRNA gene sequence database with phylotypes that represent uncultured species. Int J Syst Evol Microbiol; 1012; 62:716-721.
CrossRef - Saitou N., Nei M. The neighbor-joining method: A new method for reconstructing phylogenetic trees. Mol Bio Evol;1987; 4:406-425.
- Srivastava P., Tiwari S.P., Srivastava A.K., Sharma R. Optimization of sterilization parameters for isolation of endphytes from Allium sativum and exploring its antibacterial activity. J Pur Appl Microbiol; 2024;18:1-19.
- Gond S.K., Bergen M.S., Torres M.S., White J.F. Endophytic Bacillus produce antifungal lipopeptides and induce host defence gene expression in maize. Microbiol Res; 2015; 172:79–87.
CrossRef - Lopes R., Tsui S., Gonçalves PJRO., de Queiroz M.V. A look into a multifunctional toolbox: endophytic Bacillus species provide broad and underexploited benefits for plants. W J Microbiol Biotechnol; 2018; 34(7):94.
CrossRef - Hassan S.E. Plant growth-promoting activities for bacterial and fungal endophytes isolated from medicinal plant of Teucrium polium J Adv Res; 2017; 8:687–695.
CrossRef - Sharma A., Kaushik N., Sharma A., Bajaj A., Rasane M., Shouche Y.S., Marzouk T and Djébali N. Screening of tomato seed bacterial endophytes for antifungal activity reveals lipopeptide producing Bacillus siamensis strain NKIT9 as a potential bio-control agent. Front Microbiol; 2021; 12:609482.
CrossRef - Gorai P.S., Ghosh R., Mandal S., Ghosh S., Chatterjee S., Gond S.K and Mandal N.C. Bacillus siamensis CNE6-a multifaceted plant growth promoting endophyte of Cicer arietinum having broad spectrum antifungal activities and host colonizing potential. Microbiol Res; 2021; 252:126859.
CrossRef - Manasa T.S., Basavarajappa M., Raghavendra K.M., Ramangouda S.H and Vishwanath Y.C. Endophytic bacteria Bacillus aerius, as a potential biocontrol agent against bacterial leaf spot of betel vine. The Pharma Innov J; 2023;12(6):3195-3197.
- Xie T., Shen S., Hu R., Li W., Wang J. Screening, Identification, and Growth Promotion of Antagonistic Endophytes Associated with Chenopodium quinoa Against Quinoa Pathogens. Phytopathology®;2023; 113(10):1839-1852
CrossRef - Wei C.Y., Lin L., Luo L.J., Xing Y.X., Hu C.J., Yang L.T., Li Y.R., An Q. Endophytic nitrogen-fixing Klebsiella variicola strain DX120E promotes sugarcane growth. Bio fertility soils; 2014; 50:657-666.
CrossRef - Sahu P.K., Singh S., Gupta A.R., Gupta A., Singh U.B., Manzar N., Bhowmik A., Singh H.V., Saxena A..K. Endophytic bacilli from medicinal-aromatic perennial Holy basil (Ocimum tenuiflorum) modulate plant growth promotion and induced systemic resistance against Rhizoctonia solani in rice (Oryza sativa L.). Bio control; 2020; 150:104353.
CrossRef - Halila M.H., Strange R.N. Aug Identification of the causal agent of wilt of chickpea in Tunisia as Fusarium oxysporum sp. ciceri race. Phytopathologia mediterranea;1996;1: 67-74.
- Jasrotia P., Kashyap P.L, Bhardwaj A.K., Kumar S., Singh G.P. Scope and applications of nanotechnology for wheat production: a review of recent advances. Wheat Barley Res; 2018 10(1):1–14
CrossRef - Shree N., Kashyap P.L., Chakdar H., Srivastava A.K., Sharma A.K. Isolation and characterization of potassium solubilizing bacteria from forest soils of Meghalaya. Ind J Environ Sci; 2015;19(1&2):43–48
- Dinesh R., Srinivasan V., Hamza S., Sarathambal C., Anke Gowda S.J., Ganeshamurthy A.N., Gupta S.B., Aparna N.V., Subila K.P., Lijina A., Divya V.C. Isolation and characterization of potential Zn solubilizing bacteria from soil and its effects on soil Zn release rates, soil available Zn and plant Zn content. Geoderma;2018; 321:173–186.
CrossRef - Cui L., Yang C., Wei L., Li T., Chen X. Isolation and identification of an endophytic bacteria Bacillus velezensis 8-4 exhibiting biocontrol activity against potato scab. Bio Control; 2020;141:104156.
CrossRef - Khan M.S., Gao J., Chen X., Zhang M., Yang F., Du Y., Moe T.S., Munir I., Xue J., Zhang X. The endophytic bacteria Bacillus velezensis Lle-9, isolated from Lilium leucanthum, harbors antifungal activity and plant growth-promoting effects. J Microbio Biotechnol; 2020;30(5):668.
CrossRef - Rios-Ruiz F., Tuanama-Reátegui C., Huamán-Córdova G., Valdez-Nuñez R.A. Co-Inoculation of Endophytes Bacillus siamensis TUR07-02b and Priestia megaterium SMBH14-02 Promotes Growth in Rice with Low Doses of Nitrogen Fertilizer. Plants; 2023; 12(3): 524.
CrossRef - Wang J., Shi L., Wang D., Li L., Loake G.J., Yang X., Jiang J. White rot disease protection and growth promotion of garlic (Allium sativum) by endophytic bacteria. Plant Pathol; 2019; 68(8):1543-1554.
CrossRef - Dhaouadi S., Rouissi W., Mougou-Hamdane A., Nasraoui B. Evaluation of biocontrol potential of Achromobacter xylosoxidans against Fusarium wilt of melon. Eur J Plant Pathol;2019;154:179-188.
CrossRef - Elanchezhiyan K., Keerthana U., Nagendran K., Prabhukarthikeyan S.R., Prabakar K., Raguchander T., Karthikeyan G. Multifaceted benefits of Bacillus amyloliquefaciens strain FBZ24 in the management of wilt disease in tomato caused by Fusarium oxysporum f. sp lycopersici. Physiol Mol Plant Pathol; 2018;103, 92–101.
CrossRef - Wang G.F., Meng J.F., Tian T., Xiao X.Q., Zhang B., Xiao Y.N. Endophytic Bacillus velezensis strain B‐36 is a potential biocontrol agent against lotus rot caused by Fusarium oxysporum. J Appl Microbiol; 2020;128:1153.
CrossRef - Chen L., Shi H., Heng J., Wang D., Bian K. Antimicrobial, plant growth-promoting and genomic properties of the peanut endophyte Bacillus velezensis Microbiol Res; 2019; 218: 41-48.
CrossRef - Kumar A., Singh R., Yadav A., Giri D.D., Singh P.K and Pandey K.D. Isolation and characterization of bacterial endophytes of Curcuma longa3 Biotech; 2016; 6:60.
CrossRef - Kumar V., Kumar A., Pandey, K.D., Roy B.K. Isolation and characterization of bacterial endophytes from the roots of Cassia tora L. Ann microbial; 2015; 65(3).1391-1399.
CrossRef - Edkona J.E., King W.S., Teck S.L.C., Jiwan M., Ab Aziz Z.F., Kundat F.R., Osumanu H.A and Ab Majid N.M. Antagonistic activities of endophytic bacteria against Fusarium wilt of black pepper (Piper nigrum). I J of Agri and Bio; 2013;15(2).
- Egamberdieva D., Wirth S.J., Shurigin V.V., Hashem A and Abd_Allah, E.F. Endophytic bacteria improve plant growth, symbiotic performance of chickpea (Cicer arietinum) and induce suppression of root rot caused by Fusarium solani under salt stress. Front in microbio; 2017;8:1887.
CrossRef - Matic S., Gilardi G., Gullino M.L., Garibaldi A. Evidence for an expanded host range of Fusarium oxysporum sp chrysanthemi. J Plant Pathol; 2018;100:97–104.
CrossRef - Lecomte C., Alabouvette C., Edel-Hermann V., Robert F.and Steinberg C. Biological control of ornamenta lplant diseases caused by Fusarium oxysporum: a review. Biol Control; 2016;101:17–30.
CrossRef - Hajji-Hedfi L., Regaieg H., Larayedh A., Chihani N., Horrigue-Raouani N. Biological control of wilt disease complex on tomato crop caused by Meloidogyne javanica and Fusarium oxysporumsp lycopersici by Verticillium leptobactrum. Environ Sci Pollut Res; 2018; 25:18297–18302.
CrossRef - Raza W., Ling N., Zhang R.F., Huang Q.W., Xu Y.C and Shen Q.R. Success evaluation of the biological control of Fusarium wilts of cucumber, banana, and tomato since 2000 and future research strategies. Crit Rev Biotechnol; 2017; 37:202–212.
CrossRef